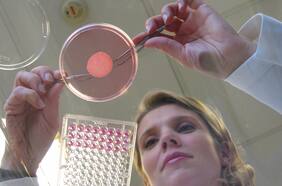
SkinTechnology: L’Oréal Groupe revoluciona la industria de la belleza con su último avance en piel reconstruida

Presentado por L’Oréal Chile
13 NOVIEMBRE
23 SEPTIEMBRE
22 DICIEMBRE
Gestionado por la Fundación L’Oréal desde 2009, el programa Belleza por un Futuro está en más de 20 países capacitando a comunidades desprotegidas, dándoles posibilidades de empleo. En Chile, trabaja a través de tres instituciones, que forman a diversas mujeres en las áreas de peluquería y colorimetría.
Belleza por un Futuro: capacitación en los oficios de la belleza
22 DICIEMBRE
Con el objetivo de impulsar las investigaciones de jóvenes científicas, L’Oréal Chile-UNESCO entregó el premio For Woman in Science. Una iniciativa que busca fomentar la incorporación de la mujer en el campo científico, disminuir la inequidad en la ciencia y apoyar los estudios locales.
Mujeres líderes en ciencia
22 DICIEMBRE
Desde hace 10 años que este proyecto recupera áreas verdes a comunidades vulnerables a través de la construcción de plazas y parques para crear espacios seguros que incentiven la formación de comunidades activas y participativas, claves del desarrollo y motor de las comunas. El trabajo, que se realiza en conjunto con los vecinos y municipalidades, ha permitido que se recuperen más de 31.000 m2 de áreas verdes durante los últimos años.
El voluntariado corporativo de L’Oréal Chile y Fundación Mi Parque que embellece el entorno de las comunidades
Lo más leído
1.
2.
3.
4.
5.
Plan digital + LT Beneficios por 3 meses
Infórmate para la segunda vuelta y usa tus beneficios 🗳️$3.990/mes SUSCRÍBETE